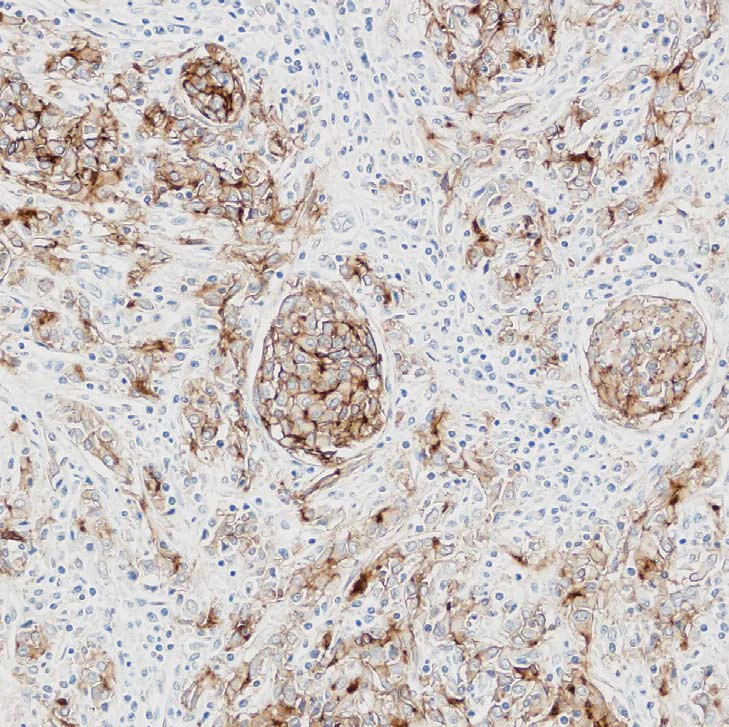
thumb

CX33 Trinocular Biological Microscope&Comfortable high-Throughput Routine Microscopy biological microscope cx33
Price history chart & currency exchange rate
Customers also viewed

$139.18
10S3P 36V 100Ah Battery ebike battery pack 18650 Li-Ion Batteries 350W 500W For High Power electric scooter Motorcycle Scooter
aliexpress.ru
$5.70
VEEAPE 510 Adapter for VOOPOO VINCI Vinci X for RPM 40 Pod Connector for 510 Vape Tank Atomizer
gearbest.com
$39.99
Men s Elevator Sneakers 2.36 Inch Invisible Height Increasing Lace up Fashion Sneakers
walmart.com
$0.97
Motorcycle Rubber Shift Lever Gear Cover Shifter Shoe Protector Gas Motorbike Parts Universal Lever Protection Moto Accessories
aliexpress.com
$31.11
Bandai One Piece Hand-painted Creative Boys/Girls High-top Canvas Shoes Students Soft Bottom Breathable Comfortable Flat Shoes
aliexpress.com
$37.01
Hotsale platform Kids Shoes mens trainers Spruce Aura pale ivory White Glacier Black Aurora Pistachio Frost womens sports sneakers 28-35, Color 6
dhgate.com
$22.08
New Gloves Latex Finger Protection Child Adults Soccer Football Goalie Gloves Non-slip Durable Soccer Gloves
aliexpress.com
$37.73
1080P Body Camera wearable Infrared night vision Mini Camera Video recorder Surveillance camera police wide angle Action camera
aliexpress.com
$29.72
japan samurai shogun oda nobunaga double side geek family tee new slim casuals hip hop shirts hooded sweatshirt hoodie men t shirt
dhgate.com
$43.17
Кардиган La Redoute, Зеленый, С V-образным вырезом из плотного трикотажа M зеленый
laredoute.ru
$76.79
4 в 1 Нова Електробритва Електричний Тример для Бороди USB Перезаряджуваний Професійний Тример для Волосся Машинка для Стрижки Волосся Бритва для Дорослих Догляд за Волоссям чорний
joom.com
$4.53
Чоловічі окуляри для короткозорості у квадратній металевій оправі. Класичні великі окуляри для ближнього зору, що блокують блакитне світло. Надлегкі окуляри з мінусовою діоптрією 0(anti-blue light) чорний
joom.com
$3.05
Мультяшний кіт, клубок в язальної вовни, ручна робота з любов ю, аксесуари для одягу, етикетки для одягу, бирки для одягу light yellow-Type 7
joom.com
$3.51
Xiaohongshu Мультяшні Завиті Густі Вії: 10 пар у стилі маленького диявола в європейському та американському дизайні 12mm
joom.com
$13.27
Поилка для пчел из смолы, цветные чашки с пчелами для сада, для жаждущих опылителей, 5 цветов, чашки с деревянной подставкой
joom.com
$54.58
2025 rhinestone transparent crystal heel sandals women s summer word with thick heels slippers high heels wear sandals 40
joom.com
$10.62
530ml Coffee Cup Stainless Steel Insulated Cup Practical Gift Thermal Mug Drinkware Style 3
joom.com
$19.09
New enamel geometric line earrings pendant set, women s high-end Chinese knot necklace.
joom.com
$39.13
Платівка LP LOUIS ARMSTRONG - Disney Songs The Satchmo Way YX7375BV BUENA VISTA 1986 Японія Обі Джаз Вживана
joom.com
$41.48
Персоналізована кулькова ручка з гравіюванням на річницю, 50 шт., персональний подарунок для чоловіків і жінок, 75 мл One Size чорний
joom.com
$20.05
DIMANAF 2025 Summer New T-shirt Women Printing Buttons Asymmetrical Short Sleeve Loose One Size
joom.com
$14.21
Дитячий ханбок для хлопчиків, костюм тан у китайському стилі, дитячий літній костюм з коротким рукавом з бавовни та льону, дитячий ретро стиль Мін 140
joom.com
$20.34
Kitchen Oil Dispenser 20 Oz Leakproof Glass Oil Bottle Glass Oil Bottle Olive Oil Container With Automatic Cap No Drip Oil
joom.com